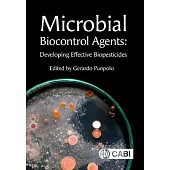
Microbial Biocontrol Agents: Developing Effective Biopesticides

Nearly 1600 species of native bees can be found in California’s rich ecosystems; this colorful pocket-sized card set wil......more

This book is for people who will study for an examination and apply for a Soil Fumigation Qualified Applicator License o......more

This study manual will prepare individuals for the Department of Pesticide Regulation’s (DPR’s) commercial applicator No......more

The book deals with the detailed description about a number of fungicides which are used for crop protection. It is writ......more

This book is designed to provide in-depth information about Geotechnical Engineering and Soil Science. It is written in ......more

It is a comprehensive basic book on farm management and designed to introduce students to the key concepts on how to eff......more

It is written in a lucid style with the most recent advances, and with theoretical discussions being supplemented with i......more

GMOs, or genetically modified organisms, are one of the hottest topics in food science and nutrition today. Are they unh......more

GMOs, or genetically modified organisms, are one of the hottest topics in food science and nutrition today. Are they unh......more

Discover the hidden world beneath your feet with Introduction to Soil Science - a comprehensive guide to the fundamental......more

This book provides basic knowledge of the programming and interfacing of devices with IoT modem and programming. The aim......more

Discover the transformative power of regenerative agriculture to create a more sustainable and equitable future for all.......more

Discover the transformative power of regenerative agriculture to create a more sustainable and equitable future for all.......more

Understanding of the dynamics of plant nutrients in the soil provides scientific basis for efficient nutrient management......more

This collection reviews the wealth of research on understanding pollination processes, the role of pollinators and how b......more

This collection features four peer-reviewed reviews on integrated pest management (IPM) in cereal cultivation. The first......more

"To disseminate information on stingless bee To share recent works on stingless bee To foster global network on stingles......more

Response of Field Crops to Abiotic Stress: Current Status and Future Prospects is a collection of useful scientific reso......more

Soil Science - Emerging Technologies, Global Perspectives and Applications describes recent research that illustrates th......more

Microorganisms are a good indicator of soil health. Plant growth-promoting microorganisms protect plants from the stress......more

Plant-microbe interaction is a powerful and promising link to mitigate the various kinds of stresses like drought, salin......more

Plant Stress Mitigators: Types, Techniques and Functions presents a detailed contextual discussion of various stressors ......more

The general public are becoming more aware of the plight of ’bees’. This is, more accurately, the plight of pollinating ......more

The aim of this book is to publish original contributions or review articles that evaluate the integration of GIS and re......more

Peatlands are regarded as having exceptional archaeological value, due to the fact the waterlogged conditions of these w......more


...more



The negative impact of chemical pesticides on human wellbeing and the environment has encouraged the development of eco-......more

Algorithim (mathematics) helps in understanding the direct and indirect relationship of plants that exist within it and ......more

This is a unique book that deals with the problem soils, their constraints and management in the Indian context. The boo......more

Besides live biomass and decaying dead biological matter, humus constitutes an important component of organic matter in ......more

This collection features five peer-reviewed reviews on weed management in regenerative agriculture. The first chapter pr......more

The Drayton Hive is a hybrid of several established hive designs, combining some of their different strengths and avoidi......more

Making a Garden of Perennials, has been considered an important book throughout the human history. So that this work is ......more

Making a Lawn, has been considered an important book throughout the human history. So that this work is never forgotten ......more

Making a Rock Garden, has been considered an important book throughout the human history. So that this work is never for......more

Making a Rose Garden, has been considered an important book throughout the human history. So that this work is never for......more

This volume, Advances in Diptera - Insight, Challenges and Management Tools, highlights the biology, life stages, physio......more

This book deals with diverse topics in wheat research and production. It discusses advances in biotic and abiotic stress......more

Revisiting Plant Biostimulants focuses on recent advances in plant biostimulants (PBs), an eco-friendly sustainable tech......more

This book deals with all aspects of chemical pest control, such as the different groups of insecticides and their modes ......more

If you want to learn about honey bees, set up your own apiary, and manage beekeeping as a hobby, then check out HowExper......more

If you want to learn about honey bees, set up your own apiary, and manage beekeeping as a hobby, then check out HowExper......more

Among the leading fruit producing countries in the world, India ranks second only after China. Fruits play pivotal role ......more

According to estimates, plant pests and diseases cause at least 10% of the world’s food production to be lost. Additiona......more

Technology for modifying the genotypes and phenotypes of insects and other arthropods has steadily progressed with the d......more

Towards a sustainable agriculture: An intervention tool for eco-friendly approach in modern era contains many sustainabl......more

"When studying honeybees, one will find that they are creatures whose secrets are not easily elicited. A bee colony is a......more

Agriculture is a backbone of Indian economy as nearly 60% rural population is engaged in agricultural activities. Though......more

This collection reviews the wealth of recent research on important aspects of soil carbon sequestration in different env......more

Though different titles of plant protection books are available, no book is as much illustrative as the present book of ......more

Pesticides - Updates on Toxicity, Efficacy and Risk Assessment examines different aspects of pesticides encountered in b......more

RUNNING A SUCCESSFUL Pest Control company is a juggling act. You require expertise in your area of pest control to provi......more

Exploring Agriculture, Food, and Natural Resources introduces middle school students to AFNR literacy to build excitemen......more

This report presents the advantages of soil bioengineering and proposes a research program on Vetiver grass and liquid s......more

This vintage book contains a complete manual for the sportsman, game preserver, gamekeeper, and amateur on the art of ta......more

Phyto-pathogens are one of the dominating components which badly affect crop production. In light of the global food dem......more

This book is intended to be a simple, thought provoking and hopefully enjoyable introduction to the keeping of bees in b......more

The third edition of Insect Resistance Management: Biology, Economics, and Prediction expands coverage by including thre......more

This is an abbreviated record of the work necessary to establish a large honey farm in the North of England written by t......more

This book is a collection of updated studies related to current improvements in legume traits and their agricultural ben......more


This collection summarises current research on the effects of different management strategies on the physical, chemical ......more

INTRODUCTION Agriculture is the Indian Economy’s most important sector. Indian agriculture accounts for 18% of India’s g......more

This book discusses the latest advances in cotton genetics and the biochemistry, physiology, bioinformatics, and genomic......more

The book was written as reference material to aid in the study of the National Diploma in Beekeeping (NDB). This is why ......more

NEW PRINT WITH PROFESSIONAL TYPE-SET IN CONTRAST TO SCANNED PRINTS OFFERED BY OTHERS Cacao Culture In The Philippines Th......more

NEW PRINT WITH PROFESSIONAL TYPE-SET IN CONTRAST TO SCANNED PRINTS OFFERED BY OTHERS Cabbages And Cauliflowers: How To G......more

Long overdue, this collection of timeless Acres U.S.A. interviews includes 25 diverse voices who sparked a movement stil......more

Splitting Colonies is an important means of colony increase and swarming mitigation. Splitting is an art as much as a sc......more

Mass Production of Beneficial Organisms: Invertebrates and Entomopathogens, Second Edition explores the latest advanceme......more

This book charts and explains how human activities have shaped and altered the development of soils in many parts of the......more

Bill Cadmore was born and raised in a tiny village on the Norfolk/Suffolk border. He moved to London for university stud......more

Parasitic weeds are those plants which have lost their autotrophic nature during the course of evolution. According to t......more

Soil is a substance which consists of minerals, organic matter, living organisms, gas, and water. Soil science studies t......more

The process of gathering crops from the field is known as harvesting. The stage that immediately follows crop production......more

Agronomy is the science concerned with the study of agriculture. It encompasses the study of the principles and practice......more

A microorganism is a microscopic organism that may exist in single-celled form or in colony of cells. The study of micro......more

Raising bees in backyards and on farms big and small is becoming more popular, and it’s simple to understand why. These ......more

Agricultural biostimulants are a group of substances or microorganisms, based on natural resources, that are applied to ......more

Practical and Theoretical Geoarchaeology, Second Edition, provides an invaluable and vastly updated overview of geoarcha......more

After publishing, with Ted Bullock, the two-volume work on Invertebrate Neurobiology, in 1962 Adrian selected a new topi......more

Soil is the most fundamental reswource to fulfill basic requirements of food, fiber and shelter of human race. Soil form......more

"From midwifing new lambs to harvesting basil, Jessica Gigot invites the reader into her life on a small farm and the un......more

Turn Dirt Into Dollars - Launch Your Own Profitable Worm Farming Business Imagine building a low-cost, high-impact busin......more

Turn Dirt Into Dollars - Launch Your Own Profitable Worm Farming Business Imagine building a low-cost, high-impact busin......more

Exploring early examples of farm machinery used for dusting and spraying crops, with detailed descriptions and explanati......more

A classic guide to growing vegetables focusing on fertilisers....more

Hazardous and Trace Materials in Soil and Plants: Sources, Effects and Management explores the latest advancements in re......more

Vanadium is an essential element for humans and animals. The toxicity of vanadium at higher concentrations could be a gl......more

With this absolute beginner’s guide, learn how to set up your backyard hives, select and raise bees, and harvest honey, ......more

Home Gardens for Improved Food Security and Livelihoods demonstrates how home gardens hold particular significance for r......more

Applications of Biosurfactant in Agriculture explores the use of beneficial microorganisms as an alternative to current ......more

This booklet is the essential user-guide to Varroa treatments. In this guide you will learn: Why Varroa mites are such a......more
All the Buzz for Beekeeping Beginners "The book oozes with bee facts and trivia....Bees do make good pets and this book ......more